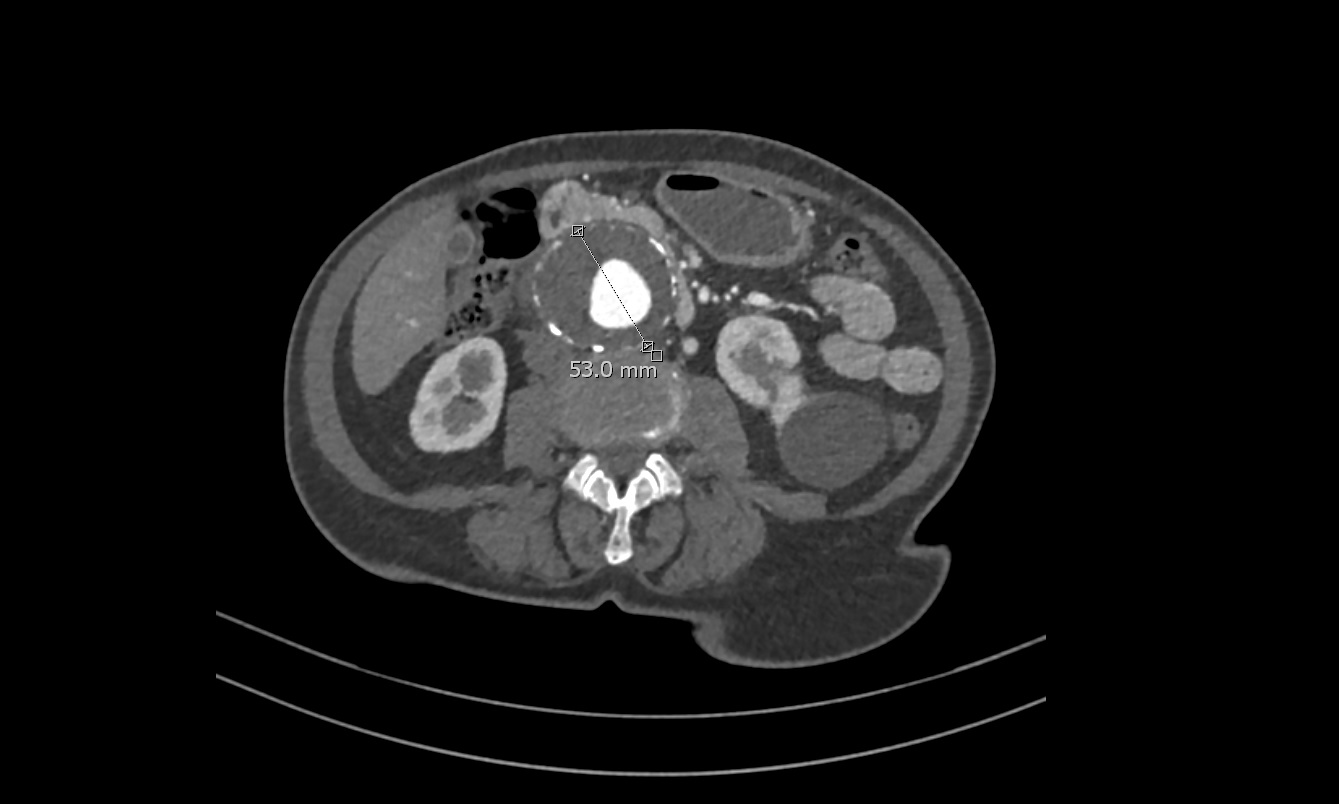

V Jornadas de Ecografía de la semFYC
9 y 10 de febrero de 2024
Comunicaciones: Casos clínicos
Aneurisma de aorta abdominal. De la palpación a la insonación (oral)
Ámbito del caso
Motivos de consulta
Historia clínica
Enfoque individual
Antecedentes personales: Mujer de 72 años. Hipertensión Arterial, Poliartrosis.
Medicación: Lisinopril, Paracetamol a demanda.
Anamnesis: Aviso a domicilio por fiebre y diarrea de 6 h de evolución, impresiona por la clínica de gastroenteritis aguda, no signos de alarma.
Exploración física: Abdomen con molestias difusas a la palpación sin signos de alarma, pero se objetiva importante masa pulsátil, sugestiva de Aneurisma de Aorta Abdominal (AAA).
En un primer momento se deriva a la paciente a realizar ecografía reglada a su hospital de referencia, que es informada como normal. Posteriormente, ante la persistencia de los hallazgos en la exploración, se cita para ecografía clínica en Centro de Salud.
Hallazgos ecográficos
En Ecografía Clínica se aprecian, en la porción distal de la Aorta, imágenes sugestivas de aneurisma de Aorta abdominal con medidas aproximadas de 5.3 cm (anteroposterior) x 9 cm (longitudinal) con importante trombo intramural.
Pruebas complementarias
TC abdominal solicitado por Cirugía vascular confirma el diagnóstico de Aneurisma de Aorta Abdominal yuxtarenal de 9 cm de diámetro máximo, con trombo mural que se extiende distalmente hasta bifurcación de las arterias iliacas.
Juicio clínico, diagnóstico diferencial, identificación de problemas
Juicio Clínico: Aneurisma Aorta Abdominal Yuxtarenal.
Diagnóstico diferencial: A la exploración física puede confundirse con otras masas abdominales como esplenomegalias o tumores. Con la eografía, la localización y captación doppler así como la pulsación característica hacen que resulte complicado confundir el diagnóstico.
Tratamiento y planes de actuación
Se derivó a Cirugía Vascular de manera preferente, servicio desde el cual se solicitó TC abdominal que confirmó el diganóstico.
Evolución
Se llevó a cabo cirugía de exclusión de AAA con colocación de prótesis, sin complicaciones.
Conclusiones (y aplicabilidad para la Medicina de Familia)
Una vez más se demuestra la importancia de la Ecografía Clínica en el diagnóstico de patologías que suponen riesgo vital para el paciente. En este caso, la ecografía reglada pasó por alto la existencia de una AAA de grandes dimensiones, que pudo ser tratada gracias a la sospecha diagnóstica y la realización de una Ecografía Clínica en el ámbito de la Atención Primaria.
Comunicaciones y ponencias semFYC: 2026; Comunicaciones: Casos clínicos. ISSN: 2339-9333
Autores
García Jiménez, Elena GabinaCS Siero-Sariego. Área Sanitaria IV. Pola de Siero. Asturias
Fernández González, Lucía
CS Siero-Sariego. Área Sanitaria IV. Pola de Siero. Asturias
Fernández Rodríguez, Roberto Carlos
CS Siero-Sariego. Área Sanitaria IV. Pola de Siero. Asturias